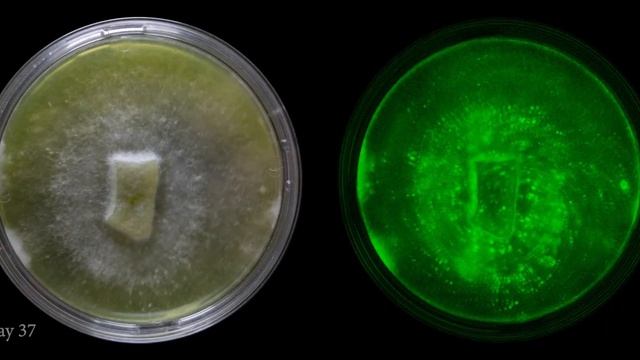
Omphalotus Nidiformis смотреть онлайн

Автор: Лесные красоты Страница 8

Традиционный бургер с булочкой и низкокалорийный диетический бургер.

Между всеми тает лед

Парк Сосновка 2019 СПб

Шампиньоны в маринаде

Едем через Аткарск)

Наша маленькая помощница. Обзор соковыжималки КитФорт 11-02-2. Миндальное молоко,овощной сок.

Уроки рисования(Урок 2)

ДОХОДНЫЙ ГАРАЖ ДЛЯ ИНВЕСТОРА | НОВЫЙ БЕТОННЫЙ ПОЛ | КИРПИЧНАЯ КЛАДКА | ШТУКАТУРКА | Максим Королев

чайный гриб.продолжение

Приемка дорог, 2020

armillaria_tabescens.mpeg

Флокс Поцелуй моей селекции

SUMMER CEP ID & TASTING UK

KTA Мостовской
Omphalotus Nidiformis

Профессиональная косметика Jeunesse SunWay B4U, Израиль Solar Energy, Sun Микс, Линчжи новые проду

Утюг из полевика

Просрал рассвет, заплутал в лесу, пробежал 30 км. Водохранилище Симферополя полно воды и грязи.

Ясновидение как проявляется характерные признаки и примеры

Биология. 7 класс. Способы борьбы с болезнетворными микроорганизмами

Fungi, #MCQs Fungi, #Ascomycetes, #Basidiomycetes, #NMDCAT, #MDCAT, #Biology

Thiovit Jet ismertetése

Красное молоко

Аккумулятор Vision CP1270 - "Хреновый" оригинал от APC
За каждым успешным каналом стоит личность, идея и сотни часов кропотливого труда. Если вы здесь, значит, автор «Лесные красоты» уже сумел зацепить ваше внимание своим уникальным стилем или подачей. А мы на RUVIDEO позаботились о том, чтобы вы могли изучить весь архив его работ в максимально комфортных условиях — без лишней суеты и преград.
Почему за работами канала «Лесные красоты» так интересно наблюдать? Всё просто: это честный контент, который находит отклик в сердцах зрителей. На нашем ресурсе вы можете смотреть онлайн все видео любимого автора бесплатно и в хорошем качестве. Нам важно, чтобы вы видели каждую деталь и слышали каждый нюанс, поэтому мы используем только стабильные плееры из открытых источников Rutube.
Следите за новинками канала, пересматривайте старые шедевры и открывайте для себя новые грани творчества «Лесные красоты». Мы постоянно обновляем ленту, чтобы у вас под рукой всегда были самые свежие выпуски. Никаких сложных регистраций — только вы и творчество, которое вдохновляет. Приятного вам путешествия по миру авторского контента на RUVIDEO!
Видео взято из открытых источников Rutube. Если вы правообладатель, обратитесь к первоисточнику.